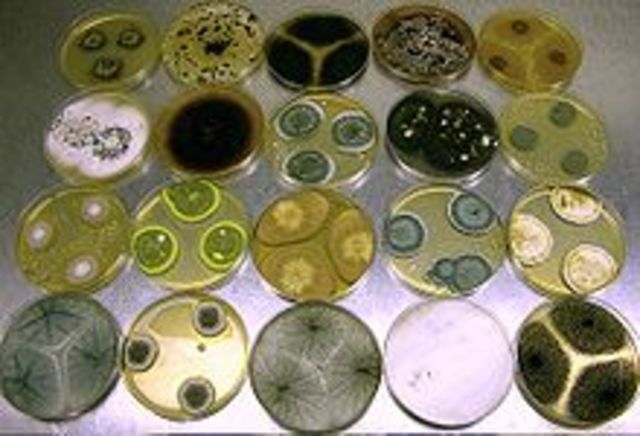
Walther and Fanny Hesse

-
Biólogo italiano. Fue profesor de historia natural en Pavía y director del Museo Mineralógico de esta ciudad. Considerado uno de los fundadores de la biología experimental, sus trabajos de investigación se centraron en los principales fenómenos vitales, como la respiración, la reproducción, la digestión, etc. Realizó importantes estudios sobre la reproducción artificial. Demostró la acción del jugo gástrico en el proceso digestivo y el intercambio de gases en la respiración.
-
El origen del microoscopio es una cuestión aún incierta. Se considera a Zacharias Janssen es el inventor del microoscopio compuesto de dos lentes.
Los primeros microscopios compuestos producidos por los Janssen eran simplemente un tubo de 45 cm de largo y 5 cm de diámetro con una lente convexa en cada extremo. Este instrumento llegó a tener entre 3 y 9 aumentos, dependiendo del tamaño de la abertura del diafragma. -
En 1665 publicó el libro Micrographía, el relato de 50 observaciones microscópicas y telescópicas con detallados dibujos. Este libro contiene por primera vez la palabra célula y en él se apunta una explicación plausible acerca de los fósiles.
Hooke descubrió las células observando en el microscopio una lámina de corcho, dándose cuenta de que estaba formada por pequeñas cavidades poliédricas que recordaban a las celdillas de un panal. Por ello cada cavidad se llamó célula. -
publicó un libro titulado "Experienze in torno de la generazione deg'Insetti" en el que planteó un experimento sencillo pero contundente para refutar las creencias acerca de la aparición súbita y espontánea de los seres vivos. La preocupación de Redi era investigar el origen de los gusanos que aparecían en la carne en descomposición.
-
En 1676, estudiando al microscopio una muestra de agua de un charco, van Leeuwenhoek encontró organismos vivos a los que llamó "animálculos": así se abría ante sus ojos y los de los demás observadores un mundo microscópico. Gran cantidad de personas, incluso los mismos reyes, viajaban a verlo para observar las maravillas ocultas que aparecían a través de las lentes.
-
El 14 de mayo será por siempre una fecha memorable en la historia de las ciencias en general y del efecto preventivo de la vacuna en particular. Ese día del año 1796, El inglés Edward Jenner hizo la primera inoculación contra la viruela. James Phipps, un niño de ocho años de edad, fue el primer inoculado con secreción recogida de una pústula vacuna (viruela de vacas) en la mano de una lechera que se había infectado durante un ordeño. El primero de julio siguiente inoculó de nuevo al pequeño.
-
comienza a estudiar una dolencia que atacaba al Bombyx mori gusano de seda, o "mal de sueño", conocido actualmente como muscardina. La larva se cubría de un polvo blanco y moría, los cultivos prácticamente se abandonaron debido a su devastación.
-
Bacillus subtilis es una bacteria Gram positiva, Catalasa-positiva, aerobio1 comúnmente encontrada en el suelo. Miembro del Género Bacillus, B. subtilis tiene la habilidad para formar una resistente endospora protectora, permitendo al organismo tolerar condiciones ambientalmente extremas.
-
Bassi demuestra que la muscardina era provocada por un cierto tipo de hongo que nombra Botrytis paradoxa (actual Beauveria bassiana), Describe la forma de eliminar y de prevenir aquel hongo lo que ayuda a la industria de la seda notablemente, Bassi publica los resultados de sus estudios y describe una teoría que explica numerosas dolencias vegetales, animales y de humanos por organismos patogénicos. Refuerza así, la teoría de que las enfermedades contagiosas como variola, tifo exantematico, síf
-
Berkeley es considerado padre de la micología británica; llegando a describir muchísimas especies. Su herbario de cerca de 10 000 especies de champiñones (con alrededor de 5 000 que describe) se conservan en las colecciones de los Reales Jadines Botánicos de Kew.
Miles Joseph Berkeley descubre un hongo (Phytophthora infestans) que produce la podredumbre de la patata. -
Fue un médico húngaro que consiguió disminuir drásticamente la tasa de mortalidad en un 70 % por sepsis puerperal (una forma de fiebre puerperal) entre las mujeres que daban a luz en su hospital mediante la recomendación a los obstetras de que se lavaran las manos con una solución de cal clorurada antes de atender los partos. La comunidad científica de su época lo denostó y acabó falleciendo víctima de septicemia a los 47 años en un asilo. Algunos años después Luis Pasteur publicaría la hipótesi
-
Demostró que el cólera era causado por el consumo de aguas contaminadas con materias fecales, al comprobar que los casos de esta enfermedad se agrupaban en las zonas donde el agua consumida estaba contaminada con heces, en la ciudad de Londres en el año de 1854. Ese año cartografió en un plano del distrito de Soho los pozos de agua, localizando como culpable el existente en Broad Street, en pleno corazón de la epidemia. Snow recomendó a la comunidad clausurar la bomba de agua, con lo que fueron
-
Mientras Louis Pasteur y Robert Koch son a menudo considerados los fundadores de la microbiología, su trabajo no reflejó fielmente la auténtica diversidad del mundo microbiano, dado su enfoque exclusivo en microorganismos de relevancia médica. Dicha diversidad no fue revelada hasta más tarde, con los trabajos de M. Beijerinck y S. Winogradsky.
Sergei Nikolaievich Winogradsky, nacido en Kiev, fué microbiólogo, ecologista y un científico ruso que inició el concepto de ciclo de la vida y descubrió -
Miescher era estudiante de medicina y en el laboratorio de Hoppe-Seyler, su maestro, comenzó a analizar los restos de pus de los desechos quirúrgicos, aislando los núcleos de los glóbulos blancos y extrayendo una sustancia ácida y cargada de fósforo a la que denominó "nucleína" (hoy sabemos que esta sustancia es la nucleoproteína). Después de tratar las células con soluciones salinas, alcohol, soluciones ácidas y soluciones alcalinas, vio que las células tratadas con una solución salina daban un
-
El trabajo de Koch consistió en aislar el microorganismo causante de esta enfermedad y hacerlo crecer en un cultivo puro, utilizando este cultivo para inducir la enfermedad en animales de laboratorio, en su caso la cobaya, aislando de nuevo el germen de los animales enfermos para verificar su identidad comparándolo con el germen original.
Probablemente tan importante como su trabajo en la tuberculosis, por el que fue galardonado con el Premio Nobel en 1905, son los Postulados de Koch, que dicen -
al mismo tiempo que Serguei Winogradsky, comenzó a investigar sobre bacterias que tuvieran desarrolladas características químicas especiales, como fijadoras de nitrógeno o quimioautótrofas, y demostró que el enriquecimiento con una determinada composición química favorecía el desarrollo de dichas características.
Beijerinck era una figura socialmente torpe; fue verbalmente abusivo con los estudiantes, nunca se casó, y tuvo algunas colaboraciones profesionales. También fue conocido por su estilo -
Existe una anécdota que dice que, estando una noche rezando el rosario, le llamó la atención un mosquito zumbando a su alrededor. Entonces fue cuando decidió investigar a los mosquitos.
Con los medios aportados por la comisión mixta hispano-estadounidense, fue capaz de identificar al mosquito Culex o Aedes aegypti como el agente transmisor de la enfermedad. Sus estudios lo llevaron a entender que era la hembra fecundada de esta especie la que transmitía la fiebre amarilla.
En 1881 fue a Washingt -
El agar, cuyo nombre completo es agar-agar, fue descubierto por el japonés Minora Tarazaemon, quien notó que una sopa de alga en un clima frío se solidificó en una noche. A partir de este momento el agar comenzó a ser usado por los europeos en la industria de los alimentos. No fue hasta 1881 que se comenzó a usar el agar como un agente solidificante en el cultivo de microorganismos. Walther Hesse, el asistente de Robert Koch, fue quien sugirió el uso de agar para los cultivos.
-
El trabajo de Koch consistió en aislar el microorganismo causante de esta enfermedad y hacerlo crecer en un cultivo puro, utilizando este cultivo para inducir la enfermedad en animales de laboratorio, en su caso la cobaya, aislando de nuevo el germen de los animales enfermos para verificar su identidad comparándolo con el germen original.
Probablemente tan importante como su trabajo en la tuberculosis, por el que fue galardonado con el Premio Nobel en 1905, son los Postulados de Koch, que dicen -
Escherichia coli descrita por primera vez en 1885 por Theodore Von Escherich, quien la denominó Bacterium coli.commune dado que se aislaba de las heces de individuos sanos y enfermos. Forma parte de los microorganismos que colonizan el intestino por lo que se define como un comensal que integra la biota intestinal de diferentes mamíferos incluido el hombre.
-
omenzó a investigar una enfermedad que afectaba a la planta del tabaco, que se manifiesta por la formación de un extraño diseño con forma de mosaico sobre las hojas y a la que se refirió como “wildfire” (que significa “correr como la pólvora”), por la rapidez con la que se desarrollaba.
No podía encontrar el microorganismo causante de ello, lo mismo que tampoco Pasteur podía encontrar el de la rabia. Ivanovski sumergió unas hojas infectadas en un líquido para que se ablande e hizo pasar el espes -
un botánico holandés, Martinus Willem Beijerinck, repitió el mismo experimento, pero no presumió que los filtros fuesen imperfectos. Insistió en que el microorganismo infeccioso era considerablemente más pequeño que las bacterias. No especulo sobre su naturaleza química o física. Lo llamo "virus filtrable". Como virus es una palabra latina que significa "veneno", Beijerinck estaba simplemente llamandolo "veneno que pasa a través de un filtro".
-
Estudió el desarrollo del ciclo vital de diferentes protozoos y coronó la labor de su vida con el descubrimiento, en colaboración con Erich Hoffman, de la espiroqueta Treponema pallidum, agente productor de la sífilis.
Schaudinn fallece viajando de regreso a Alemania de un "Congreso Internacional de Medicina", en Lisboa, cuando debe ser intervenido quirúrgicamente de urgencia, por abcesos amebianos gastrointestinales. Tal infección amebiana muy probablemente haya sido voluntariamente adqu -
Descubre el virus (retrovirus) que produce tumores (sarcomas) en pollos.
Peyton Rous identificó el primer retrovirus en 1911 cuando se encontró un agente transmisible capaz de causar un tipo de sarcoma en pollos. -
Fue un físico alemán que ganó el Premio Nobel de Física en 1986 por su trabajo en óptica electrónica, incluyendo el diseño del primer microscopio electrónico.
-
Médico y genetista. El "experimento de Griffith", que le hizo más famoso, tuvo lugar mientras investigaba una vacuna para prevenir la neumonía durante la pandemia de gripe que tuvo lugar tras la Primera Guerra Mundial. Para ello, usó dos cepas de la bacteria Streptococcus pneumoniae. La cepa S contenía una cápsula de polisacáridos y era virulenta al ser inyectada, causando neumonía y matando a las cobayas en un día o dos. Esta cápsula permitía a la bacteria resistir los ataques del sistema inmun
-
El bacteriólogo británico descubrió el antibiótico en 1928, al estudiar un cultivo de bacterias que presentaban un estado de lisis debido a la contaminación accidental con un hongo.El propio Fleming se encargó, con ayuda de un micólogo, de estudiar dicho hongo, al que se le otorgó el nombre de penicilina. Sin embargo, fueron el médico australiano Howard Walter Florey y el bioquímico alemán Ernst Boris Chain quienes iniciaron una investigación detallada y sistemática de los antibióticos naturales
-
Fue un físico neerlandés ganador del premio Nobel de Física en 1953 por su invención del microscopio de contraste de fases.
-
tomó el peligroso trabajo de la búsqueda de un antibiótico para la tuberculosis. Trabajó solo en un laboratorio instalado en un sótano en el Cook College en la Universidad de Rutgers. Luego de tres meses, el 19 de octubre de 1943 aisló dos cepas de actinobacteria, que podían efectivamente detener el crecimiento de ciertas bacterias resistentes a la penicilina.
-
El descubrimiento en 1953 de la doble hélice, la estructura retorcida escalera de ácido desoxirribonucleico ADN Watson y Crick publicaron sus hallazgos en un artículo de una página, "Una estructura de ácido desoxirribonucleico," en el semanario científico británico el 25 de abril de 1953. La más importante de las "nuevas características" del "considerable interés biológico" que describieron era el emparejamiento de las bases en el interior de las dos cadenas principales de ADN: A = T y C = G.
-
Peter Piot viajó en 1976 hasta el norte del Congo para frenar una enfermedad entonces desconocida con una llamativa forma: excesivamente larga y con forma de cuerda, el virus llegó a Europa en un termo azul Nadie fue consciente de la peligrosidad del equipaje de mano que llevaba un mensajero en el vuelo desde Kinshasa, entonces Zaire, hasta Amberes, en 1976. Ni siquiera tenía idea de ello Peter Piot.
-
en 1983 ofrecer a la comunidad internacional lo que será uno de los mayores descubrimientos de las últimas décadas del siglo XX, el virus del SIDA. Esta enfermedad, más propiamente denominada Síndrome de Inmunodeficiencia Adquirida, causó alarma social en la década de los 70, al desconocerse los mecanismos de transmisión y la terapia a seguir en caso de infección. su resultado es una reducción en la efectividad del sistema inmunológico que hacen al sujeto vulnerable a cualquier tipo de infeccion
-
En 1997 el barco de investigación ruso Petr Kottsov recogió muestras de sedimentos a unos 90 metros de profundidad en la bahía de Walvis en Namibia. Dos años después, científicos de la Universidad de Barcelona, del Instituto de Microbiología Marina Max Planck (Alemania) y del Instituto Oceanográfico Woods Hole de Massachusetts (Estados Unidos) coordinados por la doctora Heidi Schulz hacían público el hallazgo del microorganismo Bacteria Gigante "Perla de azufre de a través de la revista Science.
-
Streptomyces coelicolor es un representante del grupo de bacterias filamentosas, viven en el suelo responsable de producir la mayoría de los antibióticos naturales utilizados en la medicina humana y veterinaria
-
en 2009 apareció la cepa 2009 H1N1pdm cuya hemaglutinina era distinta a la de los otros virus H1N1 contemporáneos, y que surgió a causa de una triple recombinación de la neuroaminidasa de virus porcinos. Caracterizacion "in vivo" e "in vitro" de la gripe H1N1 (agosto)